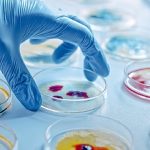

Doğumun bir mucize olduğu ve bu deneyimin anne adayları için eşi benzeri olmayan duygusal ve fiziksel bir yolculuk olduğu herkes tarafından kabul ediliyor. Doğum yapma deneyiminin kadının hem psikolojik hem de fiziksel sağlığı üzerinde uzun vadeli etkileri oluyor. Bireyselleştirilmiş duygusal desteğin kadınları güçlendirdiği ve olumlu bir doğum tecrübesi olasılığını artırdığı belirtiliyor. Olumlu doğum deneyiminde ailenin, ortamın ve sağlık çalışanlarının yaklaşımı büyük önem taşıyor. Memorial Sağlık Grubu Medstar Topçular Hastanesi Kadın Hastalıkları ve Doğum Bölümü’nden Op. Dr. Nilüfer Yüksel, normal doğum sürecinde dikkat edilmesi gerekenler hakkında bilgi verdi.
Doğum süreci tüm kadınlar için mucizevi bir durumdur ancak normal doğum anne adaylarında çok daha fazla duygu durumlarının gelişmesine neden olabilir. Normal doğum esnasında kadın sanki bu dünyada değil de başka bir gezegendeymiş gibi hisseder ve dünyadan koparak içe dönüş yaşar. Günlük yaşamda yapmaya cesaret edemediği çığlık atmak, garip sesler çıkarmak ve değişik pozisyonlara girmek gibi hareketleri doğum esnasında yapabilir. Bunun nedeni beynin daha çok düşünen kısmı neokorteks faaliyetlerinde azalma olmasıdır.
Sağlıklı bir normal doğum süreci için bunlara dikkat edin;
Uzmanlar doğum sürecinde beyinde düşünme, görme, işitme, konuşma gibi üst düzey zihinsel işlevleri yöneten neokorteksi uyarmaktan mümkün olduğunca uzak durulması gerektiğinin altını çizmektedir.
Başlıca neokorteksi uyaran 4 faktör aşağıdaki gibidir;
1- Sessiz ve sakin bir ortam seçilmeli: Doğum odasında kadın bir içe dönüş yaşarken konuşarak kadının içe dönüşüne engel olmamak gerekir. Doğum odasındaki yardımcı kişi olabildiğince sessiz olmalı ve net cevaplar istenen sorular sormamalıdır.
2-Loş ışık tercih edilmeli: Uyku ihtiyacı olduğunda, beyin faaliyetleri azalarak uykuya geçiş sağlanır. Bu nedenle etrafta ışık gibi kişiyi uyaran bir şey olmaması önemlidir. Doğum esnasında da çok aydınlık bir oda doğum yapan kadını yoracaktır. Gece ise az ışık açılarak, gündüzde ise perdeler kapatılarak ortam doğum yapan kadına uygun hala gelmelidir.
3-İzlenme hissini engellenmeli: Doğum esnasında en rahatsız edici durumlardan biri ziyaretçiler olabilmektedir. Doğum odasına ziyaretçi kabul edilmemesi kadının rahatlığı için önemlidir. Aynı duruma sağlık çalışanlarının da dikkat etmesi gerekir. Normal doğumu tek ebenin takip etmesi anne adayının doğum sürecinin daha rahat gerçekleşmesini sağlayacaktır.
4-Adrenalin salınımına dikkat edilmeli: Adrenalin neokorteksi uyaran, vücudun stres anında ürettiği bir hormondur. Eğer doğum yapan kadın doğum odasında kendini ve bebeğini güvende hissetmezse adrenalin salınımı başlar. Doğum sürecinde güven duyduğu ebe ve doktoru ile normal doğuma başlamışsa süreç daha rahat ilerleyecektir. Fakat kadının kafasında; doğum yapabilecekken doktorunun kendisini sezaryene alması veya tam tersi doktorunun kendisini normal doğuma zorlayarak kendinin veya bebeğinin zarar görebileceği gibi endişeler varsa bu durum adrenalin salınımı uyarır. Böyle bir şey söz konusu olduğunda da doğum yavaşlayabilir veya durabilir. Doğumda güven duyulan bir ekiple doğum sürecinin başlatılması oldukça önemlidir.
Kaynak: (BYZHA) Beyaz Haber Ajansı
Bir Cevap Yaz